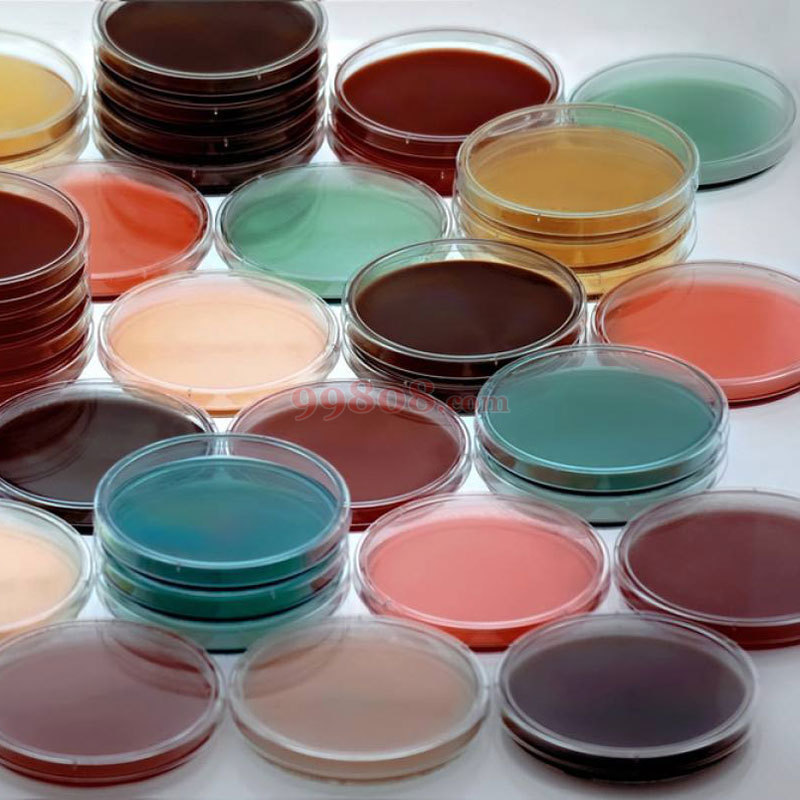
缩略图 8

同品型号列表:
选择对应型号的订购数量,即可加入购物车
| 图片 | 货号 | 规格 | 包装 | 编码 | 品牌 | 订购数量 | 单位 | 单价 | 详细 |
|---|---|---|---|---|---|---|---|---|---|
| 14900当前 | Φ90x15mm | 10套/袋 50袋/箱 | - | ReLAB | 起售:1 批量:1 | 箱 | ¥353.00/箱 | 当前项目 | |
| 2741054 | Φ60x13mm | 10套/袋 100袋/箱 | - | ReLAB | 起售:1 批量:1 | 箱 | ¥358.00/箱 | ||
| 2741055 | Φ90x20mm | 10套/袋 50袋/箱 | - | ReLAB | 起售:1 批量:1 | 箱 | ¥358.00/箱 | ||
| 2741058 | Φ90x15mm 两分格 | 20套/袋 25袋/箱 | - | ReLAB | 起售:1 批量:1 | 箱 | ¥380.00/箱 | ||
| 2741059 | Φ90x15mm 三分格 | 20套/袋 25袋/箱 | - | ReLAB | 起售:1 批量:1 | 箱 | ¥389.00/箱 | ||
| 2741060 | Φ90x15mm 四分格 | 20套/袋 25袋/箱 | - | ReLAB | 起售:1 批量:1 | 箱 | ¥425.00/箱 | ||
| 16596 | Φ150x15mm | 10套/袋 20袋/箱 | - | ReLAB | 起售:1 批量:1 | 箱 | ¥430.00/箱 | ||
| 16036 | Φ70x15mm | 10套/袋 100袋/箱 | - | ReLAB | 起售:1 批量:1 | 箱 | ¥434.00/箱 | ||
| 2741056 | Φ100x16mm | 10套/袋 50袋/箱 | - | ReLAB | 起售:1 批量:1 | 箱 | ¥506.00/箱 | ||
| 2741053 | Φ35x11mm | 10套/袋 200袋/箱 | - | ReLAB | 起售:1 批量:1 | 箱 | ¥588.00/箱 | ||
| 2741057 | Φ120x20mm | 10套/袋 32袋/箱 | - | ReLAB | 起售:1 批量:1 | 箱 | ¥615.00/箱 | ||
| 2741061 | 方形100*100mm | 10套/袋 50袋/箱 | - | ReLAB | 起售:1 批量:1 | 箱 | ¥624.00/箱 | ||
| 2741062 | 方形带线100*100mm | 10套/袋 50袋/箱 | - | ReLAB | 起售:1 批量:1 | 箱 | ¥624.00/箱 | ||
| 2741063 | 方形130*130mm | 10套/袋 30袋/箱 | - | ReLAB | 起售:1 批量:1 | 箱 | ¥624.00/箱 | ||
| 2741064 | 方形250*250mm | 1套/袋 40袋/箱 | - | ReLAB | 起售:1 批量:1 | 箱 | ¥1352.00/箱 |
| 形状 | 规格 | 底直径*高 | 盖直径*高 | 包装 | 装箱数(套) | 净重g |
| 圆形 | 35mm | 35*11mm | 38*6mm | 10套/包 | 2000 | 3.3 |
| 60mm | 56*13mm | 60*8mm | 10套/包 | 1000 | 7.1 | |
| 70mm | 68*15mm | 70*9mm | 10套/包 | 1000 | 7.7 | |
| 90mm | 86*13mm | 90*6mm | 10套/包 | 500 | 13 | |
| 90mm高型 | 87*20mm | 90*6mm | 10套/包 | 500 | 15 | |
| 90mm二分格 | 86*16mm | 90*6mm | 20套/包 | 500 | 12.1 | |
| 90mm三分格 | 86*16mm | 90*6mm | 20套/包 | 500 | 12.3 | |
| 90mm四分格 | 86*16mm | 90*6mm | 20套/包 | 500 | 16.5 | |
| 100mm | 95*16mm | 100*10mm | 10套/包 | 500 | 20 | |
| 120mm | 115*20mm | 120*8mm | 10套/包 | 320 | 30 | |
| 150mm | 144*15mm | 150*10mm | 10套/包 | 200 | 45 | |
| 方形 | 100*100方形 | 100*15mm | 103*10mm | 10套/包 | 500 | 26 |
| 100*100方形带线 | 100*15mm | 103*10mm | 10套/包 | 500 | 27 | |
| 130*130方形 | 125*15mm | 130*9mm | 10套/包 | 300 | 41 | |
| 250*250方形 | 245*15mm | 250*9mm | 1套/包 | 40 | 236 |